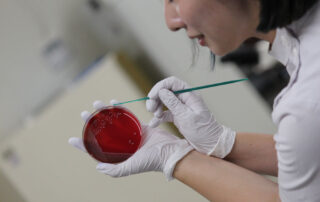

新着情報
令和7年度 第4回の体験入学が行われました
2025.8.2
令和7年度、第4回目の体験入学が、高校生7名と保護者4名の参加の下、令和7年8月2日(土)の10時から行われました。
今回は、血液検査と微生物検査を体験してもらいました。血液検査では、模擬採血と血液塗抹標本の作製・染色、顕微鏡を用いた血液標本の観察が行われました。微生物検査では、血液寒天培地を用いた細菌の培養(塗抹操作)や細菌の同定に必要なカタラーゼ試験を実施しました。その他にも細菌の染色法の原理などの説明などもありました。また、2年生からは、臨床検査についての説明と実際の学校生活の一例をスライドを用いながら紹介しました。
参加された皆様には、学校生活と臨床検査技師としての未来を少しでも想像できましたでしょうか。
是非、臨床検査技師の道を選択して頂き、さらには、本校への入学をお待ちしております。
体験入学実施内容
1)体験実習
・血液検査
・微生物検査
・仕事と学校紹介
2)学校個別面談
体験入学の様子
体験者の声(原文のまま)
- 臨床検査技師の仕事がどういうものなのかがよく分かったし、授業や実習についてもよく分かりました。今回の体験でさらに興味がわきました。
- 全体的に分かりやすいお話の内容で、とて良い勉強になったなと感じました。今回体験した実習以外にも、専門的な分野の活動が沢山あって難しそうだけど、学びがいがあって良いなと思いました。また、採血をする際の針を刺す動作がとても難しかったです。
- 普段なら体験できないことをさせていただき、より臨床検査になりたい欲がわきました。ありがとうございました。
- 説明を聞いて、興味深くやりがいのある仕事だと思いました。
- とても楽しく分かりやすく学ぶことができました。
- 説明が分かりやすく、ものすごく楽しかった。もっと興味を持てた。
令和7年度 体験入学の日程と実習項目(予定)
・第1回 令和7年 5月17日(土)10~12時 生化学検査、病理検査、学生発表
・第2回 令和7年 6月14日(土)14~16時 輸血検査、生理機能検査、仕事・学校紹介
・第3回 令和7年 7月19日(土)10~12時 血液検査、免疫検査、研修旅行発表
・第4回 令和7年 8月2日(土)10~12時 血液検査、微生物検査、仕事・学校紹介
・第5回 令和7年 8月23日(土)10~12時 免疫検査、生理機能検査、模擬授業
・第6回 令和7年 9月27日(土)10~12時 生化学検査、寄生虫検査、仕事・学校紹介
・第7回 令和7年 11月15日(土)10~12時 病理検査、微生物検査、模擬授業
是非、ご参加ください。(なお、都合により実習内容は変更になる場合があります。)